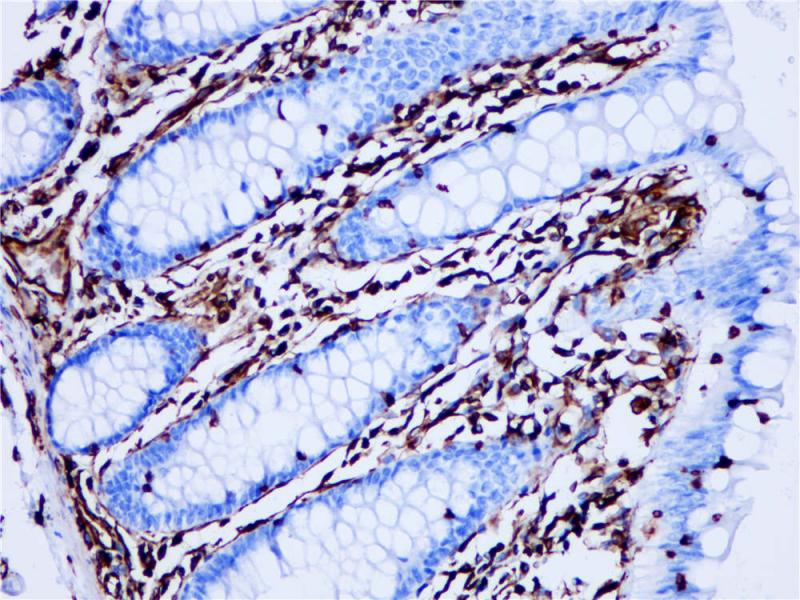
结肠 Vimentin (BP6010) 染色

产品中心

乳腺癌 Vimentin (BP6010) 染色
结肠 Vimentin (BP6010) 染色
Vimentin 重组兔单克隆抗体
Vimentin(波形蛋白)是中间丝的其中一种蛋白,是真核生物细胞骨架重要组成成分,其对细胞的完整性和细胞骨架稳定性至关重要。Vimentin表达于多种间充质细胞类型:成纤维细胞、内皮细胞等,以及从中胚层衍生的许多其他细胞类型,如间皮瘤和卵巢颗粒细胞。但是,在非血管平滑肌细胞中Vimentin常被Desmin所替代。在肿瘤组织中,Vimentin存在于许多不同的肿瘤中,尤其是在那些起源于间充质细胞的肿瘤组织。Vimentin与其他抗体组合检测,用于鉴别间充质来源肿瘤和恶性黑色素瘤。此外,Vimentin可作为一种有效的组织处理标志物。
Specifications
- 目录号
- BX50006
- 克隆号
- BP6010
- 阳性对照
- 宫颈癌
- 亚细胞定位
- 细胞核
- 组织类型
- FFPE
- 修复方式
- HIER
- 稀释比
- 1:100-1:200
- 规格
- 100μl/vial, 1ml/vial
- 用途
- RUO
Reference
1.Xiaotian Jia, et al,Oncol Lett. 2016 Sep; 12(3): 1717–1720.
2.Bo Su, et al,Oncotarget. 2016 Mar 1; 7(9): 10498–10512.


